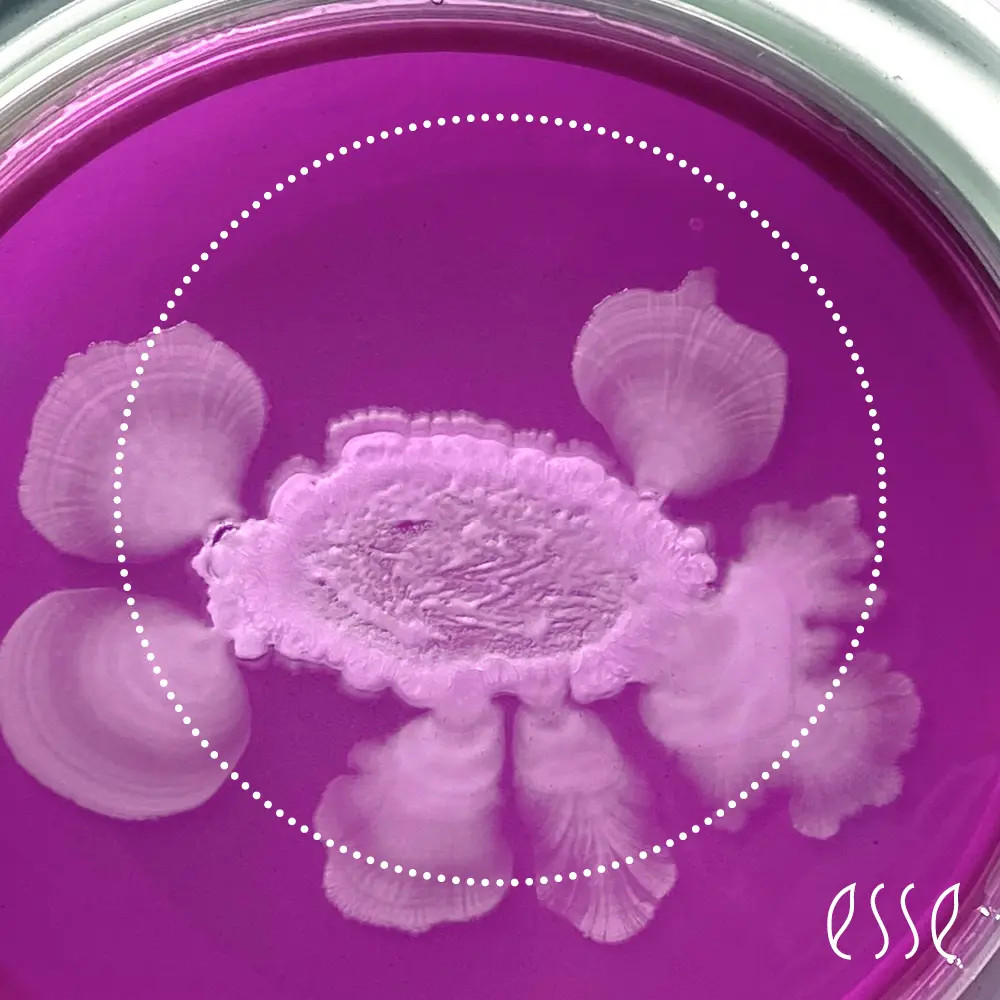

D - VITAMIINI JA IHO
Esse Pro - Sun D serum - D - vitamiinia ihosi parhaaksi auringon avulla
Iho on kehomme suurin elin, ja sen hyvinvointi heijastuu suoraan ulkonäköömme ja terveyteemme. Esse Pro - Sun D Serum on innovatiivinen tuote, joka yhdistää luonnon ja tieteen voimat tarjotakseen ihollesi optimaalista hoitoa ja suojaa.
Tämä kevyt, auringonvalosta aktivoituva seerumi on suunniteltu lisäämään ihon D-vitamiinitasoja minimaalisella aurinkoaltistuksella – vain viisi minuuttia auringossa riittää aktivoimaan seerumin tehoaineet.
Miksi D-vitamiini on tärkeää iholle?
D - vitamiini on elintärkeä ihon terveydelle. Se tukee ihon suojabarriäärin toimintaa, edistää solujen uusiutumista ja rauhoittaa tulehdustiloja. Kun iho saa riittävästi D - vitamiinia, se on kimmoisampi, kosteutetumpi ja vähemmän altis ärsytyksille, kuten aknelle, rosacealle tai ihottumille.
Lisäksi D - vitamiini auttaa ehkäisemään auringon aiheuttamaa ennenaikaista ikääntymistä ja vahvistaa ihon vastustuskykyä. Turvallisin ja luonnollisin D - vitamiinin lähde ihollemme on luonnollisesti vitamiini, jota ihomme tuottaa itse altistuessaan UVB - säteilylle kohtuullisissa määrin.
Purkkivitamiinia tarvitsemme talvikaudella, mutta sen hyödyt jäävät ihoa ajatellen hyvin minimaalisiksi. Siksi on tärkeää tukea tätä luonnollista D -vitamiinisynteesiä silloin kun auringonvaloa on saatavilla.
On hyvä myös muistaa, että pilvisellä säällä UVB - säteilyä ei saada välttämättä lainkaan, samoin on asian laita jos käytämme jatkuvasti aurinkosuojaa jossa suojakerroin on yli 30. Vain UVB - säteilyn ansiosta ihomme D - vitamiinintuotanto käynnistyy.
Esse Pro - Sun D Serum – Hyödyt pähkinänkuoressa
- D - vitamiinin synteesi: Seerumin provitamiini D muuttuu iholla ensin Pre vitamiiniksi ja siitä lämmön vaikutuksesta aktiiviseksi D -vitamiiniksi. Tähän prosessiin tarvitaan auringon UVB-säteilyä, jota meillä suomessa on saatavilla Maaliskuusta alkaen.
- Kosteutus ja rauhoitus: Aloe vera pehmentää ja kosteuttaa ihoa samalla kun se rauhoittaa ärsytystä.
- Ikääntymisen ehkäisy: D - vitamiini auttaa ehkäisemään auringon vanhentavia vaikutuksia ja rauhoittaa tulehdusta. Se myös vahvistaa ihon rakennetta ja hidastaa siten ihon ohenemista.
- Auttaa vähentämään ihohuokosten tukkeutumista ja ihon hyperkeratinisaatiota joilla on merkitystä mm. akneihon synnyssä.
- Seerumin myötä parantunut D - vitamiinitaso ihossa rauhoittaa myös tulehdusreaktioita ja siksi sillä on erinomainen, parantava vaikutus mm. rosaceaan, atooppiseen ihottumaan, podiin (= suunympärysihottuma) ja akneen.
- Lyhyellä kesäkaudella seerumista hyötyvät ihan kaikentyyppiset ihot
Miten käytät seerumia?
- Levitä tuotetta kerran päivässä ennen auringolle altistumista. Käytä tuotetta kasvoille ja kaulalle puhdistuksen ja kasvosuihkeen jälkeen. Voit käyttää tuotetta kaikille auringolle altistuville ihoalueille.
- Parhaan D - vitamiinisynteesin saamiseksi, anna ihon altistua suoralle auringonvalolle ainakin 5 minuutin ajan ilman aurinkosuojaa tai meikkivoidetta.
- Aurinkokylvyn jälkeen voit levittää ihollesi Essen hoitoseerumin ja kosteusvoiteen/aurinkosuojan/meikkituotteet
Miksi iho tarvitsee aurinkoaltistusta?
Vaikka liiallinen auringolle altistuminen voi olla haitallista, kohtuullinen määrä auringonvaloa on välttämätöntä D - vitamiinin tuotannolle. D -vitamiini ei ole pelkkä "aurinkovitamiini" – se on hormonin kaltainen aine, joka vaikuttaa koko kehomme toimintaan.
Se säätelee immuunijärjestelmää, luuston ja lihasten terveyttä sekä mielialaa. Seerumi mahdollistaa D - vitamiinin hyödyt ilman pitkäaikaista altistumista auringolle, mikä tekee siitä täydellisen valinnan kaikille ihotyypeille.
Esse Pro Sun D Serum on enemmän kuin pelkkä seerumi – se on investointi ihosi terveyteen ja hyvinvointiin. Sen avulla voit nauttia auringonvalon hyödyistä turvallisesti ja tehokkaasti. Jos haluat ihosi hehkuvan terveenä ja kosteutettuna, tämä seerumi on ehdoton lisä ihonhoitorutiiniisi kesäkaudella.
Oletko valmis antamaan ihollesi sen ansaitseman hoidon?
